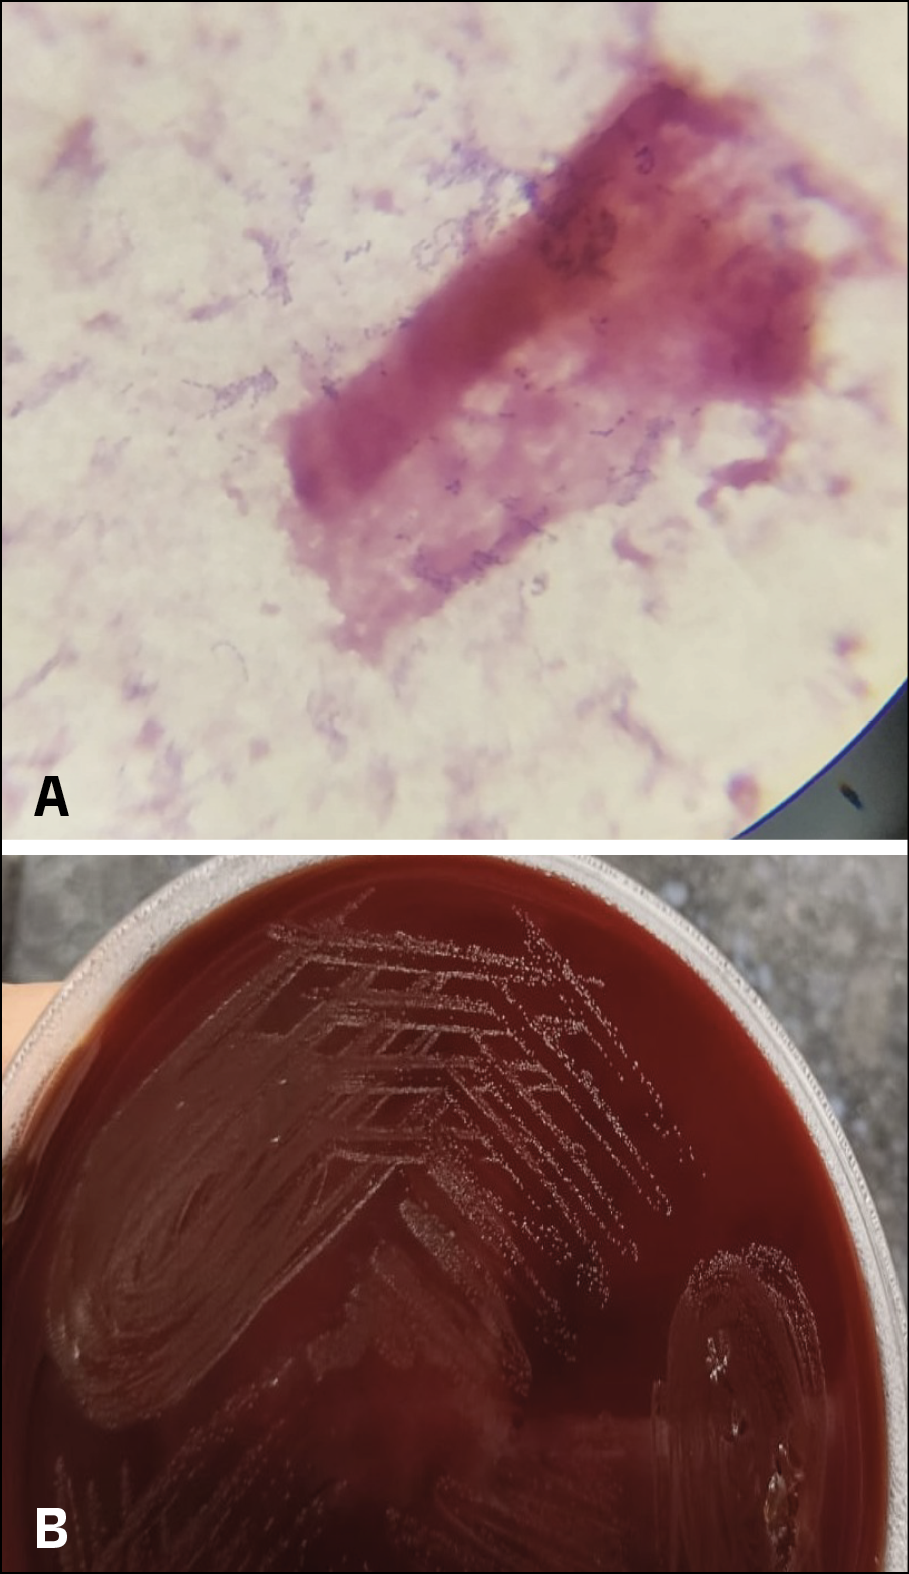

Le Infezioni in Medicina, n. 1, 139-143, 2025
doi: 10.53854/liim-3301-14
CASE REPORTS
Case of Granulicatella elegans endocarditis triggering both ischemic and haemorrhagic stroke: A rare clinical presentation from eastern India
Saikat Mondal1, Venkatesh Kottawar1, Sunitaj Parvin2, Boudhayan DasMunshi1, Saurav Banerjee3, Nazneen Nahar Begam4, Mallika Sengupta2
1Department of Medicine, All India Institute of Medical Sciences, Kalyani, India;
2Department of Microbiology, All India Institute of Medical Sciences, Kalyani, India;
3Department of Cardiology, All India Institute of Medical Sciences, Kalyani, India;
4Department of Infectious Diseases, IPGMER & SSKM Hospital, Kolkata, India.
Article received 18 December 2024 and accepted 18 February 2025
Corresponding author
Mallika Sengupta
E-mail: mallika.micro@aiimskalyani.edu.in
SummaRY
We report a rare clinical presentation of a 54-year-old male diagnosed with infective endocarditis caused by Granulicatella elegans, a nutritionally variant streptococcus (NVS) characterized by unique growth requirements and high pathogenic potential. The patient presented with prolonged fever and residual hemiparesis following an ischemic stroke. Blood culture confirmed Granulicatella elegans, and imaging identified vegetations on a bicuspid aortic valve. Despite prompt antibiotic therapy, the course was complicated by acute intraventricular hemorrhage (IVH) and hydrocephalus, culminating in a fatal outcome. This report underscores the pathogenic challenges posed by Granulicatella elegans, highlights its catastrophic complications, and reviews its presentation and management in the context of existing literature and emphasizing the importance of prompt diagnosis, tailored antibiotic therapy, and vigilant monitoring.
Keywords: Granulicatella elegans, infective endocarditis, hemorrhagic stroke, ischemic stroke.
BACKGROUND
Infective endocarditis (IE) remains a critical illness with significant morbidity and mortality, especially when associated with less common pathogens like nutritionally variant streptococci (NVS). This group, first described in 1961, includes Abiotrophia and Granulicatella species, which are organisms characterized by their inability to grow on standard media without specific supplements such as pyridoxal or L-cysteine [1].
NVS are part of normal oral flora but can cause endocarditis, including culture-negative and prosthetic-valve endocarditis accounting for around 5-6% of all IE cases often associated with a higher propensity for systemic embolization and treatment challenges compared to other streptococcal species [2-4]. Neurological complications in IE, including ischemic and haemorrhagic strokes, occur in 20-40% of cases [5]. However, simultaneous presentation of both types of cerebrovascular accidents (CVAs) is extremely rare, as seen in the present case. Among NVS, Granulicatella elegans is an especially rare but significant cause of IE. Although native valve endocarditis is more common in individuals with underlying structural heart disease, cases have been reported in patients without apparent risk factors [6]. There are only three reports of Granulicatella adiacens causing endocarditis in India [2-4]. Here, we report this rare pathogen Granulicatella elegans causing endocarditis with both ischemic and hemorrhagic CVA in a middle-aged male. This report aims to detail the clinical course of Granulicatella elegans IE, discuss its devastating complications, and review of the existing literature to provide insights into its diagnosis and management. This report is presented after approval from the Institutional Ethics Committee and informed consent was taken from the patient’s wife.
CASE PRESENTATION
A 54-year-old male, with no prior history of diabetes, hypertension, or structural heart disease, presented with a two-week history of high-grade fever, generalized weakness, and residual hemiparesis following a prior ischemic stroke (one and half month back). On examination, the patient was pale and exhibited an ejection systolic murmur over the aortic area. Neurological evaluation revealed left-sided residual motor weakness with a power of 4/5 in both upper and lower limb of left side.
Routine laboratory tests showed anaemia (Hb 7.5 g/dL), leucocytosis, and elevated inflammatory markers, including CRP (71.1 mg/L) and procalcitonin (61.93 ng/mL). Liver and renal function tests were within normal limits. Investigations for fever workup including malaria, dengue, scrub typhus and leptospirosis were negative. His chest X-ray was unremarkable. Fundoscopic examination revealed bilateral Roth spots, suggestive of micro-embolic phenomena.
Three sets of blood cultures were obtained on admission, all of which were positive within one day showing growth of Granulicatella elegans. The blood culture was processed in BacT Alert system (Biomerieux Inc), Gram stain showed small spherical Gram-positive cocci in chains (Figure 1A), subculture showed growth of fine non hemolytic colonies and features of satellitism (Figure 1B). The organism was identified as Granulicatella elegans by VITEK 2 Compact System (Biomerieux Inc.) and it was susceptible to penicillin, ceftriaxone, erythromycin, levofloxacin, vancomycin, and linezolid. MRI of the brain showed an old infarct in the middle cerebral artery (MCA) territory, likely secondary to a prior embolic event. Transoesophageal echocardiography (TEE) revealed vegetations on a bicuspid aortic valve with mild aortic regurgitation (Figure 2).
The patient was diagnosed with native valve bacterial endocarditis caused by Granulicatella elegans and was initiated on intravenous ceftriaxone (2 g every 12 hours) and gentamicin (40 mg every 12 hours). His fever subsided, and inflammatory markers decreased significantly. Follow-up blood cultures on day 12 of therapy were negative and did not show any growth of organism.
However, on day 16, the patient experienced a sudden neurological decline, characterized by severe headache, projectile vomiting, bradycardia (54 beats/min), and hypertension (190/110 mmHg). Glasgow Coma Scale (GCS) assessment revealed a score of less than 8, necessitating immediate intubation. MRI showed acute massive bi-ventricular haemorrhage (IVH) with midline shift to the left and hydrocephalus (Figure 3A and 3B).
Despite aggressive medical management, including mechanical ventilation and broadening of antibiotic coverage with vancomycin and meropenem, the patient’s condition continued to deteriorate. He succumbed to his illness on day 29 of hospitalization.
Figure 1A and 1B - Figure 1A shows small spherical Gram-positive cocci in chains and 1B shows growth of fine non hemolytic colonies.

Figure 2 - Transoesophageal echocardiography (TEE) revealed vegetations on a bicuspid aortic valve with mild aortic regurgitation.

Figure 3A and 3B - MRI showed acute massive bi-ventricular haemorrhage (IVH) with midline shift to the left and hydrocephalus.
DISCUSSION
Granulicatella species have emerged as a rare but virulent cause of IE, with increased diagnostic difficulty owing to their nutritional needs [1, 6]. While IE typically manifests as systemic embolization in one-third of cases, concurrent ischemic and haemorrhagic complications are exceedingly rare [5, 7].
This case highlights three critical dimensions:
– Pathogenesis of neurological complications - Infective endocarditis, being a complex disease, often leads to the formation of vegetations on heart valves, composed of fibrin, platelets, and bacterial colonies [6]. IE-related ischemic stroke arises primarily from embolic occlusion of cerebral arteries, whereas haemorrhagic strokes can result from mycotic aneurysm rupture, septic arteritis, or haemorrhagic transformation of ischemic infarct [8, 9]. In this case, vegetations from the Granulicatella elegans infection likely dislodged and travelled to the cerebral arteries, causing an embolic stroke. This blockage caused an ischemic stroke in the affected brain area, leading to left-sided hemiparesis. Emboli from infective endocarditis may carry bacteria that infect cerebral blood vessels. This can weaken vessel walls and predispose them to rupture, leading to haemorrhagic stroke around two months later from initial cerebrovascular accident.
– Challenges in diagnosis - Diagnosing NVS-associated IE is particularly challenging due to the organism’s fastidious growth requirements. Conventional blood culture systems may fail to isolate the organism without pyridoxal-enriched media [6]. In this case, the BacT Alert system along with subculture with Staphylococcus aureus successfully obtained a culture and identification of Granulicatella elegans.
– Treatment challenges and prognostic considerations - Standard therapy for NVS includes prolonged beta-lactam antibiotics combined with aminoglycosides [10]. Despite initial microbiological clearance, the patient’s clinical deterioration highlights the limitations of current therapeutic approaches in preventing embolic and haemorrhagic complications. The persistence of vegetations and embolic risks despite microbial clearance underscores the need for vigilant monitoring.
Mortality in NVS endocarditis approaches 20%, with worse outcomes seen in cases complicated by intracerebral haemorrhage [10]. The prognosis of NVS IE is determined by several factors, including the extent of valvular damage, embolic complications, and the timeliness of intervention. The high mortality associated with intracranial complications, as seen in this case, underscores the need for vigilance and multidisciplinary care.
The rarity of Granulicatella elegans IE complicates the establishment of standardized management protocols. A review of some published cases reveals diverse outcomes as delineated in Table 1. These cases underscore the spectrum of IE-related neurological complications and reinforce the need for tailored therapeutic strategies.
Table 1 - Review and outcome of some published cases of Infective Endocarditis caused by Nutritionally variant Streptococcus.

CONCLUSIONS
This case demonstrates the lethal potential of Granulicatella elegans IE, particularly its association with severe neurological complications. Early recognition, supported by advanced microbiological techniques, is crucial for initiating appropriate therapy. Further research is needed to optimize treatment strategies and mitigate embolic and haemorrhagic risks in NVS IE.
Conflict of interest
None to declare.
Funding
None to declare
Ethics approval
The study was approved by the Institutional Ethics Committee, All India Institute of Medical Sciences, Kalyani (IEC/AIIMS/Kalyani/certificate/2024/369)
REFERENCES
[1] Ruoff KL. Nutritionally variant streptococci. Clin Microbiol Rev. 1991; 4(2): 184-190.
[2] Vandana KE, Mukhopadhyay C, Rau NR, Ajith V, Rajath P. Native valve endocarditis and femoral embolism due to Granulicatella adiacens: a rare case report. Braz J Infect Dis. 2010; 14(6): 634-636.
[3] Shailaja TS, Sathiavathy KA, Unni G. Infective endocarditis caused by Granulicatella adiacens. Indian Heart J. 2013; 65(4): 447-449.
[4] Padmaja K, Lakshmi V, Subramanian S, Neeraja M, Krishna SR, Satish OS. Infective endocarditis due to Granulicatella adiacens: a case report and review. J Infect Dev Ctries. 2014; 8(4): 548-550.
[5] Ionita CC, Siddiqui AH, Levy EI, Hopkins LN, Snyder KV, Gibbons KJ. Acute ischemic stroke and infections. J Stroke Cerebrovasc Dis Off J Natl Stroke Assoc. 2011; 20(1): 1-9.
[6] Giuliano S, Caccese R, Carfagna P, Vena A, Falcone M, Venditti M. Endocarditis caused by nutritionally variant streptococci: a case report and literature review. Infez Med. 2012; 20(2): 67-74.
[7] Carneiro, T. S., Awtry, E., Dobrilovic, N., et al. Neurological complications of endocarditis: A multidisciplinary review with focus on surgical decision making. Seminars in Neurology. 2019; 39(4): 495-506.
[8] Salaun E, Touil A, Hubert S, et al. Intracranial haemorrhage in infective endocarditis. Arch Cardiovasc Dis. 2018; 111(12): 712-721.
[9] Garcia-Cabrera E, Fernandez-Hidalgo N, Almirante B, et al. Neurological complications of infective endocarditis: Risk factors, outcome, and impact of cardiac surgery: A multicenter observational study. Circulation. 2013; 127(23): 2272-2284.
[10] Royden-Jones H, Siekert RG, Geraci JE. Neurologic manifestations of bacterial endocarditis. Ann Intern Med. 1969; 71: 21-28.
[11] Kahn DE, O’Phelan K, Bullock R. Infectious endocarditis presenting as intracranial hemorrhage in a patient admitted for lumbar radiculopathy. Case Rep Crit Care. 2011; 2011: 428729
[12] Alagesan AK, Sriharsha T, Raghav J, Vikrannth V, Kannan R, Meenakshi K. Granulicatella adiacens infective endocarditis. Int J Adv Med. 2022; 9: 1211-1214.